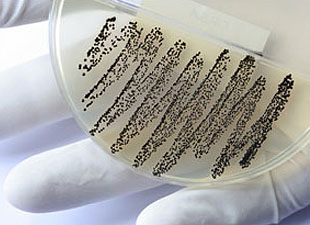

Anusuya Das
ABOUT
Anusuya Das received a Ph.D. in Biological Engineering from Massachusetts Institute of Technology (MIT), USA, and a B.A. in Bioelectrical/Cellular-Molecular Engineering from Arizona State University, USA. Anusuya is currently a post-doctoral researcher at the University of Virginia, USA.
Stories by Anusuya Das
Specialized Immune Cells Use Vitamin B To Recognize Infection
Researchers have discovered how specialized immune cells recognize products of vitamin B synthesis that are unique to bacteria and yeast, triggering the body to fight infection.
23 Nuclear Power Plants In Tsunami Hot Spots
Researchers have identified 23 atomic power plants that are more prone to suffering the effects of a tsunami.
Yoga May Ease Back Pain, Elderly Insomnia
Two recent studies have highlighted the health benefits of yoga, which range from treating chronic or recurrent low back pain, to helping elderly people with insomnia.
Why Women Outlive Men… In Flies
Scientists are beginning to understand one of life's enduring mysteries - why women live, on average, longer than men.
HPV, EBV May Interact In Prostate Cancers
Two common viruses known to be associated with human cancers are both present in most prostate cancers, a new study suggests.
Scientists Discover New Type Of ‘Cross-Presenting’ White Blood Cell
Researchers in Newcastle and Singapore have identified a new type of white blood cell that activates a killing immune response to an external source.
French Fries Diet Linked To Heart Disease, Diabetes Risk In Southeast Asia
The rapid growth of fast food companies in Southeast Asia is linked to an increased risk of heart disease and type 2 diabetes in this population, say researchers.
The Yin And Yang Of Blood Stem Cells: How The Wnt Signal Controls Growth
Researchers have identified an important molecular cue that stops blood stem cells from proliferating when their services are not needed.
Marijuana Use May Double Risk Of Premature Birth, Study
A large international study has found that women who use marijuana can more than double the risk of giving birth to a baby prematurely.
Specialized Immune Cells Use Vitamin B To Recognize Infection
Researchers have discovered how specialized immune cells recognize products of vitamin B synthesis that are unique to bacteria and yeast, triggering the body to fight infection.
23 Nuclear Power Plants In Tsunami Hot Spots
Researchers have identified 23 atomic power plants that are more prone to suffering the effects of a tsunami.
Yoga May Ease Back Pain, Elderly Insomnia
Two recent studies have highlighted the health benefits of yoga, which range from treating chronic or recurrent low back pain, to helping elderly people with insomnia.
Why Women Outlive Men… In Flies
Scientists are beginning to understand one of life's enduring mysteries - why women live, on average, longer than men.
HPV, EBV May Interact In Prostate Cancers
Two common viruses known to be associated with human cancers are both present in most prostate cancers, a new study suggests.
Scientists Discover New Type Of ‘Cross-Presenting’ White Blood Cell
Researchers in Newcastle and Singapore have identified a new type of white blood cell that activates a killing immune response to an external source.
French Fries Diet Linked To Heart Disease, Diabetes Risk In Southeast Asia
The rapid growth of fast food companies in Southeast Asia is linked to an increased risk of heart disease and type 2 diabetes in this population, say researchers.
The Yin And Yang Of Blood Stem Cells: How The Wnt Signal Controls Growth
Researchers have identified an important molecular cue that stops blood stem cells from proliferating when their services are not needed.
Marijuana Use May Double Risk Of Premature Birth, Study
A large international study has found that women who use marijuana can more than double the risk of giving birth to a baby prematurely.